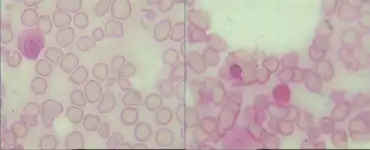

Pearson syndrome
| Pearson syndrome | |
|---|---|
| Other names: Pearson's marrow/pancreas syndrome,[1] Sideroblastic anemia with marrow cell vacuolization and exocrine pancreatic dysfunction | |
![]() | |
| Ring sideroblasts in the bone marrow (Iron stain) | |
Pearson syndrome is a mitochondrial disease characterized by sideroblastic anemia and exocrine pancreas dysfunction. Other clinical features are failure to thrive, pancreatic fibrosis with insulin-dependent diabetes and exocrine pancreatic deficiency, muscle and neurologic impairment, and, frequently, early death. It is usually fatal in infancy. The few patients who survive into adulthood often develop symptoms of Kearns–Sayre syndrome. It is caused by a deletion in mitochondrial DNA. Pearson syndrome is very rare, less than a hundred cases have been reported in medical literature worldwide.
The syndrome was first described by pediatric hematologist and oncologist Howard Pearson in 1979;[2] the deletions causing it were discovered a decade later.[3]
Signs and symptoms
Pearson syndrome is a very rare mitochondrial disorder that is characterized by health conditions such as sideroblastic anemia, liver disease, and exocrine pancreas deficiency.[4]
Genetics

Pearson syndrome is a mitochondrial disease caused by a deletion in mitochondrial DNA (mtDNA).[4] An mtDNA is genetic material contained in the cellular organelle called the mitochondria. Depending on the tissue type, each cell contains hundreds to thousands of mitochondria. There are 2–10 mtDNA molecules in each mitochondrion. With mitochondrial disorders caused by defects in the mtDNA, the severity of the disease depends on the number of mutant mtDNA molecules present in the cells.
Pearson syndrome consists of mtDNA deletions that differs in size and location compared to other mtDNA disorders such as chronic progressive ophthalmoplegia (CPEO) and Kearns-Sayre syndrome (KSS). The deletions in these molecules are usually spontaneous and normally include one or more tRNA genes.[5] Even though prenatal testing for Pearson syndrome is theoretically possible, analyzing and interpreting the results would be extremely difficult.[6]
With the use of molecular genetic testing, the deletions of mitochondrial DNA with Pearson syndrome ranges in size from 1.1 to 10 kilobases. A common mtDNA deletion associated with Pearson syndrome is the deletion of 4977 bp. This deletion has been labeled as m.8470_13446del4977.[7] Diagnosing Pearson syndrome utilizes leukocyte DNA with the Southern Blot analysis. This type of mitochondrial DNA deletion are normally more abundant and easily isolated in the blood than in any other tissue type.
Mitochondrial disease
Pearson syndrome is classified as a mitochondrial disease because it consists of several overlapping syndromes that are caused by mutations of mitochondrial DNA. Specifically, Pearson syndrome is a combination of syndromes that involves the bone marrow and the exocrine pancreas.[8]
Pearson marrow-pancreas syndrome
Pearson marrow pancreas syndrome (PMPS) is a condition that presents itself with severe reticulocyto-penic anemia.[4] With the pancreas not functioning properly, this leads to high levels of fats in the liver. PMPS can also lead to diabetes and scarring of the pancreas.[8]
Pathophysiology

Defining features
- Blood. With Pearson syndrome, the bone marrow fails to produce white blood cells called neutrophils. The syndrome also leads to anemia, low platelet count, and aplastic anemia.[10]
It may be confused with transient erythroblastopenia of childhood.[11]
- Pancreas. Pearson syndrome causes the exocrine pancreas to not function properly because of scarring and atrophy.[12]
Individuals with this condition have difficulty absorbing nutrients from their diet which leads to malabsorption. Infants with this condition generally do not grow or gain weight.[8]
Diagnosis
To diagnose Pearson Syndrome a physician can either collect a bone marrow biopsy and look for sideroblastic anemia, a symptom of Pearson Syndrome, or measure the fat content in a feces sample. Genetic testing is also an option in which identifying mutations in mitochondrial DNA, specifically deletions or duplications, would confirm the diagnosis of Pearson Syndrome.[13]
Treatment
Currently there are no approved therapies for Pearson Syndrome and patients rely on supportive care. Minovia Therapeutics Archived 2022-03-12 at the Wayback Machine is the first company to conduct a designated clinical trial for treating patients affected by this disease[14]
History
Pearson syndrome was initially characterized in 1979 as a fatal disorder that affects infants. It has now been identified as a rare condition that affects multiple systems. The symptoms of Pearson syndrome are mitochondrial cytopathy with anemia, neutropenia, and thrombocytopenia.[12]
References
- ↑ "Pearson syndrome (Concept Id: C0342784) - MedGen - NCBI". www.ncbi.nlm.nih.gov. Archived from the original on 2024-04-10. Retrieved 2024-04-06.
- ↑ Pearson, Howard A.; Lobel, Jeffrey S.; Kocoshis, Samuel A.; Naiman, J. Lawrence; Windmiller, Joan; Lammi, Ahti T.; Hoffman, Ronald; Marsh, John C. (1979). "A new syndrome of refractory sideroblastic anemia with vacuolization of marrow precursors and exocrine pancreatic dysfunction". The Journal of Pediatrics. 95 (6): 976–84. doi:10.1016/S0022-3476(79)80286-3. PMID 501502.
- ↑ Rotig, A; Colonna, M; Bonnefont, J.P; Blanche, S; Fischer, A; Saudubray, J.M; Munnich, A (1989). "Mitochondrial DNA deletion in Pearson's marrow/pancreas syndrome". Lancet. 1 (8643): 902–3. doi:10.1016/S0140-6736(89)92897-3. PMID 2564980. S2CID 40198120.
- 1 2 3 Kefala-Agoropoulou, Kalomoira; Roilides, Emmanuel; Lazaridou, Anna; Karatza, Eliza; Farmaki, Evangelia; Tsantali, Haido; Augoustides-Savvopoulou, Persephone; Tsiouris, John (2007). "Pearson syndrome in an infant heterozygous for C282Y allele of HFE gene". Hematology. 12 (6): 549–53. doi:10.1080/10245330701400900. PMID 17852457. S2CID 19167784.
- ↑ Roberts, Roland G.; Sadikovic, Bekim; Wang, Jing; El-Hattab, Ayman; Landsverk, Megan; Douglas, Ganka; Brundage, Ellen K.; Craigen, William J.; Schmitt, Eric S.; Wong, Lee-Jun C. (2010). "Sequence Homology at the Breakpoint and Clinical Phenotype of Mitochondrial DNA Deletion Syndromes". PLOS ONE. 5 (12): e15687. Bibcode:2010PLoSO...515687S. doi:10.1371/journal.pone.0015687. PMC 3004954. PMID 21187929.
- ↑ van den Ouweland, J M W; de Klerk, J B C; van de Corput, M P; Dirks, R W; Raap, A K; Scholte, H R; Huijmans, J G M; Hart, L M; Bruining, G J; Maassen, J A (2000). "Characterization of a novel mitochondrial DNA deletion in a patient with a variant of the Pearson marrow–pancreas syndrome". European Journal of Human Genetics. 8 (3): 195–203. doi:10.1038/sj.ejhg.5200444. PMID 10780785.
- ↑ DiMauro, Salvatore; Hirano, Michio (May 3, 2011). "Mitochondrial DNA Deletion Syndromes". In Pagon, Roberta A; Adam, Margaret P; Ardinger, Holly H; Wallace, Stephanie E; Amemiya, Anne; Bean, Lora JH; Bird, Thomas D; Fong, Chin-To; Smith, Richard JH; Stephens, Karen (eds.). GeneReviews. Seattle: University of Washington. Archived from the original on October 18, 2021. Retrieved September 13, 2021.
- 1 2 3 "Pearson marrow-pancreas syndrome". Genetics Home Reference. May 2013. Archived from the original on 2020-09-24. Retrieved 2021-09-13.
- ↑ Yoshimi, Ayami; Ishikawa, Kaori; Niemeyer, Charlotte; Grünert, Sarah C. (17 October 2022). "Pearson syndrome: a multisystem mitochondrial disease with bone marrow failure". Orphanet Journal of Rare Diseases. 17 (1): 379. doi:10.1186/s13023-022-02538-9. ISSN 1750-1172.
- ↑ Pearson Syndrome. http://marrowfailure.cancer.gov/PEARSON.html Archived 2014-10-12 at the Wayback Machine
- ↑ Kliegman, Stanton (2011). Nelson's Textbook of Pediatrics. Elsevier. p. 1652. ISBN 9788131232774.
- 1 2 Pearson Syndrome at eMedicine
- ↑ U.S. Department of Health and Human Services, National Institutes of Health, Genetic and Rare Diseases Information Center (updated in 2016). Pearson’s Syndrome. Retrieved from: https://rarediseases.info.nih.gov/diseases/7343/pearson-syndrome#:~:text=Diagnosis%20of%20Pearson%20syndrome%20is,therapy%2C%20and%20treatment%20of%20infections Archived 2021-03-18 at the Wayback Machine.
- ↑ Minovia Therapeutics Ltd. (2020-06-21). "A Phase I/II, Open Label, Single Dose Clinical Study to Evaluate the Safety and Therapeutic Effects of Transplantation of MNV-BM-BLD (Autologous cd34+ Cells Enriched With Blood Derived Mitochondria) in Pediatric Patients With Pearson Syndrome".
{{cite journal}}: Cite journal requires|journal=(help)
External links
- Pearson Syndrome research study of Inherited Bone Marrow Failure Syndromes (IBMFS) Archived 2021-03-01 at the Wayback Machine
- GeneReviews: Pearson syndrome Archived 2007-04-18 at the Wayback Machine
| Classification | |
|---|---|
| External resources |
|